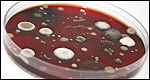
Animals: Collective Nouns 動(dòng)物世界：集合名詞

|
 |
 |
 |
 |
 |
Your score: 0/6
Your score: 1/6
Your score: 2/6
Your score: 3/6
Your score: 4/6
Your score: 5/6
Your score: 6/6 |
 |
| |
 |
 |
 |
 |
1 : The warnings are usually clear: if you see a large ________ of fish get out of the water, because sharks won't be far away. |
 |
 |
 |
The possible answers were:
crowd
school
gang
pan
You said:
crowd
school
gang
pan
|

|
 |
 |
|
對(duì)不起,答錯(cuò)了。Crowd 是一群,一堆的意思。
恭喜你,答對(duì)了。School 這個(gè)詞雖然有學(xué)校的意思,但是還可以被用來(lái)形容魚(yú)群。Shoal 這個(gè)詞也有魚(yú)群的意思。
對(duì)不起,答錯(cuò)了。Gang 的意思是一伙,一幫。想想形容魚(yú)應(yīng)該用哪個(gè)詞。
對(duì)不起,答錯(cuò)了。Pan 的意思是平底鍋,用在這里不合適,再想想。
你沒(méi)有回答這個(gè)問(wèn)題。
|
 |
 |
 |
 |
| |
 |
 |
 |
 |
2 : A glimpse of a ________ of lions in an enclosure was our welcome to the lodge. |
 |
 |
 |
The possible answers were:
pride
circus
clutter
roar
You said:
pride
circus
clutter
roar
|

|
 |
 |
|
回答正確,恭喜!Pride 的意思是驕傲,自豪。但也可以用來(lái)描述獅群。
對(duì)不起,答錯(cuò)了。Circus 的意思是馬戲團(tuán)。再想想獅子的特性都有哪些?
對(duì)不起,答錯(cuò)了。Clutter 的意思是雜物,零亂的東西。不過(guò)也可以用來(lái)形容很多蜘蛛。英語(yǔ)里還有一個(gè)表達(dá) 'cluster of spiders', 意思就是蜘蛛群。
對(duì)不起,答錯(cuò)了。Roar 的意思是咆哮,吼叫。再想想。
你沒(méi)有回答這個(gè)問(wèn)題。
|
 |
 |
 |
 |
| |
 |
 |
 |
 |
3 : The desert locust (蝗蟲(chóng)) forms ________ that can migrate over large distances. |
 |
 |
 |
The possible answers were:
hoppers
herds
swarms
packs
You said:
hoppers
herds
swarms
packs
|

|
 |
 |
|
對(duì)不起,答錯(cuò)了。雖然蝗蟲(chóng)和螞蚱都是跳躍前進(jìn),但是這個(gè)答案用在這里不合適。再想想看。
對(duì)不起,答錯(cuò)了。Herd 是牧群,獸群的意思;不過(guò)我們通常只用這個(gè)詞來(lái)形容牛群和象群。
恭喜你,答對(duì)了。Swarm 意思是蜂群。類(lèi)似短語(yǔ)像是:a cloud of grasshoppers 一群螞蚱。
對(duì)不起,答錯(cuò)了。Pack 的意思是一群,可以用來(lái)形容獵犬或野獸,像狼。
你沒(méi)有回答這個(gè)問(wèn)題。
|
 |
 |
 |
 |
| |
 |
 |
 |
 |
4 : Mr Wright worked on his parents' farm in his youth and later kept his own ________ of sheep. |
 |
 |
 |
The possible answers were:
bunch
flock
mountain
jumper
You said:
bunch
flock
mountain
jumper
|

|
 |
 |
|
對(duì)不起,答錯(cuò)了。Bunch 的意思是一捆、一束。
恭喜你,答對(duì)了。Flock 的意思是一群,常指羊群。
對(duì)不起,答錯(cuò)了。Mountain 的意思是山,大量的,不過(guò)我們不用這個(gè)詞來(lái)修飾動(dòng)物。
對(duì)不起,答錯(cuò)了。Jumper 的意思是毛衫,有可能是羊毛 wool 做成的。
你沒(méi)有回答這個(gè)問(wèn)題。
|
 |
 |
 |
 |
| |
 |
 |
 |
 |
5 : Scientists cultivate ________ of bacteria to find cures for some diseases they cause. |
 |
 |
 |
The possible answers were:
brigades
illnesses
colonies
itch
You said:
brigades
illnesses
colonies
itch
|
|
 |
 |
|
對(duì)不起,答錯(cuò)了。Brigades 的意思是一組,一旅。
對(duì)不起,答錯(cuò)了。Illness 的意思是疾病。可能是由細(xì)菌引起的疾病,再想想。
恭喜你,答對(duì)了。 Bacterial colonies 的意思是細(xì)菌群體。單詞 colony 的意思是殖民地,聚居地。
對(duì)不起,答錯(cuò)了。Itch 的意思是癢,雖然可能是由細(xì)菌引起的,但用在這里不合適。再想想看。
你沒(méi)有回答這個(gè)問(wèn)題。
|
 |
 |
 |
 |
| |
 |
 |
 |
 |
6 : A ________ of crows (烏鴉) can destroy many farm crops. |
 |
 |
 |
The possible answers were:
murder
sleuth
feather
evil
You said:
murder
sleuth
feather
evil
|

|
 |
 |
|
對(duì)不起,答錯(cuò)了。Sleuth 的意思是偵探。有時(shí)候也可以用來(lái)修飾 bears 熊。
對(duì)不起,答錯(cuò)了。Feather 的意思是羽毛。再想想這里需要哪個(gè)詞?
對(duì)不起,答錯(cuò)了。Evil 的意思是邪惡的,用在這里不合適,再想想看。
答對(duì)了,加分。一群烏鴉可以被稱(chēng)為 a murder. 烏鴉素來(lái)都預(yù)兆不吉祥的事情,它們也慣于襲擊羊群和食用剛死去的動(dòng)物或人類(lèi)尸體。
你沒(méi)有回答這個(gè)問(wèn)題。
|
 |
 |
 |
 |
| |
|
|